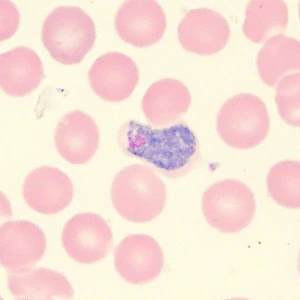
Case_515_B Figure B
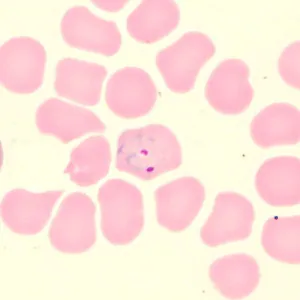
Case_515_C Case_515_C
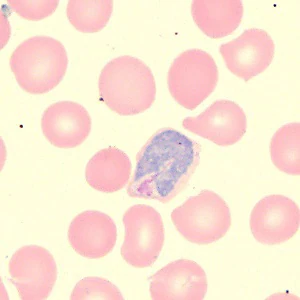
Case_515A Figure D
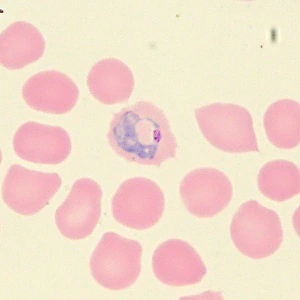
Case_515_E Figure E

Case #515 – May, 2020
A group of college students traveled to Brazil on a rafting and camping trip for two weeks. Malaria prophylaxis was highly recommended however one student declined. The one student who declined prophylaxis developed headache, fever, and chills two days after returning from the trip. He sought medical attention at the university travel clinic and a blood smear was prepared, stained with Wrights stain and examined for parasites. Figures A–G show what was detected. What is your diagnosis? Based on what criteria?

Figure A
Figure B
Figure C
Figure D

Figure G
Figure E

Figure F
Images presented in the dpdx case studies are from specimens submitted for diagnosis or archiving. On rare occasions, clinical histories given may be partly fictitious.
DPDx is an educational resource designed for health professionals and laboratory scientists. For an overview including prevention, control, and treatment visit www.cdc.gov/parasites/.